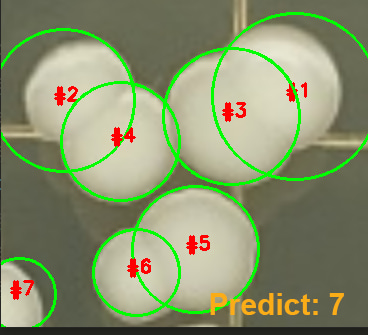

Laidlaw Research: Wrapping it All Up
Week 5: Training Object Detectors
After my meeting on week 4, I had more confidence about creating an object detector for bacteria colonies using deep learning. More specifically, I learned about transfer learning which allows you to create a reasonably accurate model using pre-made deep learning models. The benefit of using this in my case was the smaller amount of images I needed for training my own model. Whereas if I were to train from scratch, I would require around 10,000 images for an accurate model.
For this project, I only had 145 images available, 80 of which were actually useable (since those images contained confirmed bacteria colonies). After gathering my images and labelling all the colonies (separating individual and clusters), I trained object detectors using Mask R-CNN, creating some fairly accurate models (90% and 70% respectively). Week 5 and 6 was also when I spent the most time at home since I had a computer with a powerful graphics card. Without it speeding up the process, I would have spent a lot longer on this project!

Week 6: Creating the Bacteria Counter
With my object detector models created, I was able to create the final counter. I decided to separate the counting of individual colonies and colony clusters into two steps, meaning incoming images would be passed through twice. Once detected on the images, the total number of bacterias on the plate had to be counted. While counting individual colonies was as simple as asking the computer to "+1," the clusters were a different story. For simplicity, the clusters were counted using an algorithm built into the computer vision package I used, which would estimate the amount of "shapes" present in a blob. While not the most robust system, it provided adequate results for a proof of concept.
After all that, I had a working counter! I tested it on a few images that weren't used for training and got some promising results. My program was found to be less error-prone than existing automated counters and only provided slight overcounting in certain instances.
Beyond the Six Week Period...
While I was done with all my technical work and my designated period of research was completed, I still had a lot of writing to do. Over the course of week 7, I wrote my first academic paper on this project. I mentioned my findings as well as all the future work I plan to do should I decide to continue this project next year (which is very likely). I was quite surprised with how much my supervisor enjoyed reading it too. We're currently looking for the conferences/journals to submit this to, so fingers crossed I get to publish this paper!
Additionally, I made a poster to go along with this project which I am super excited to see! While it is not approved yet, keep an eye on my profile on the Laidlaw Scholars Network for when I post it!
And that's all from me! This has been a surreal experience for me and definitely pushed me out of my comfort zone. While there were up's and down's, I am thankful for the experience and I give all my gratitude towards the Laidlaw Foundation for giving me this opportunity. This will probably be the last blog I post for a while as I need mentally prepare myself for term time. However, once I start working on some more projects, I'll be sure to write about them!
Thank you, the reader, for taking the time to read through all my blogs. I hope you enjoyed them, and I hope to see you again next time! While you're here, check out my other projects, and perhaps my "content creator" side once you are done!
If you want to see more Laidlaw content, you can check out the scholar blogs on both the Laidlaw Network and Trinity College's own dedicated website for Laidlaw blogs!
https://laidlawscholars.network/
Until next time, thanks again for reading!

Please sign in
If you are a registered user on Laidlaw Scholars Network, please sign in